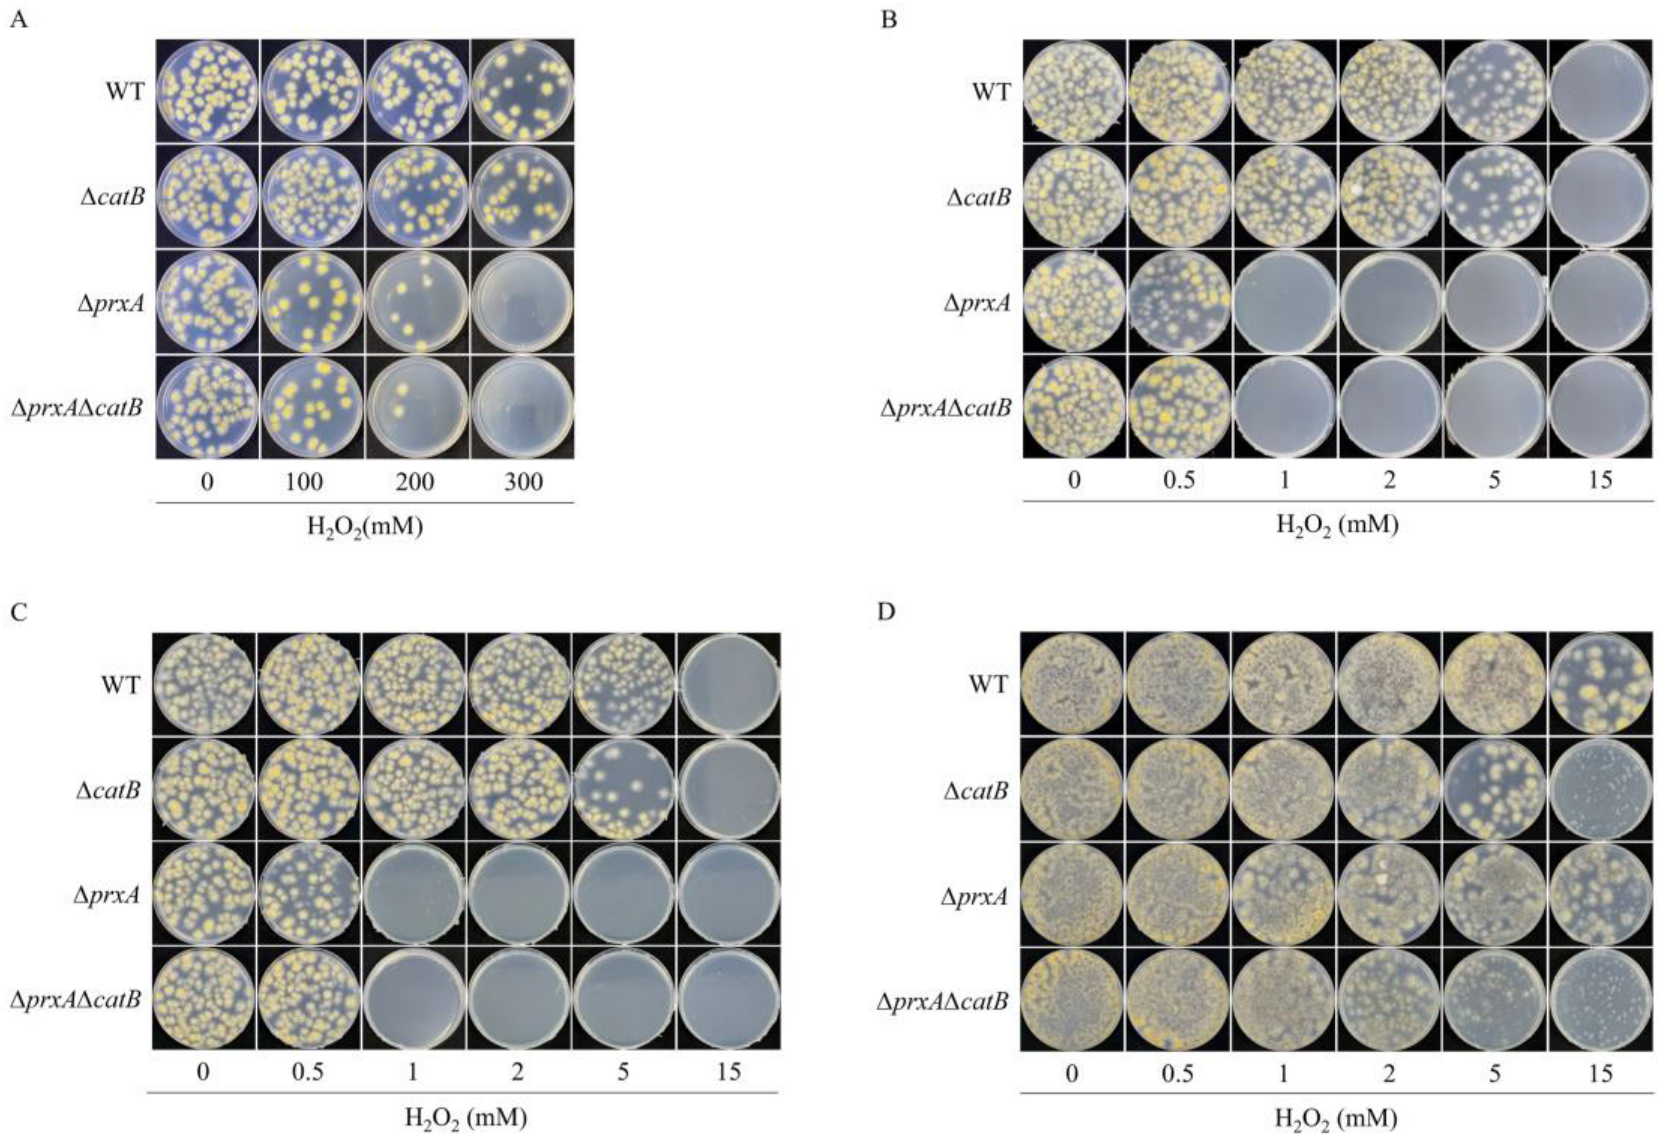
Antioxidants 12 01333 g001

Cytosol Peroxiredoxin and Cell Surface Catalase Differentially Respond to H2O2 Stress in Aspergillus nidulans
Abstract
1. Introduction
2. Materials and Methods
2.1. Strains and Growth Conditions
2.2. Construction of Plasmids for Subsequent Recombinant Strain Construction
2.3. Construction of Recombinant Strains
2.4. Confirmation of the Genomic Integration of the Target Genes in the Recombinant Strains
2.5. Conidia Prepared for H2O2 Resistance Assays
2.6. Quantification of Intracellular GFP Levels and β-Glucuronidase (GUS) Activity
2.7. Quantitative Real-Time PCR
2.8. Cell Lysate Catalase Activity Assay
2.9. Fluorescence Microscopy
3. Results
3.1. PrxA Plays a Role in H2O2 Resistance in Dormant Conidia
3.2. PrxA and CatB Play Nonredundant Roles in Defense against H2O2 at Different Growth Stages
3.3. Expression Profiles of PrxA and CatB Were Correlated with Their H2O2 Resistance
3.4. Overexpressing CatB Cannot Enhance H2O2 Resistance of the Swelling and Germinating Conidia
3.5. Extracellular Secretion of CatB Is Necessary for H2O2 Resistance
3.6. Functionalized PrxA and CatB Localize in Cytosol and Cell Surface, Respectively
3.7. Cytosolic Localized CatB Cannot Functionally Substitute PrxA at Germinating Conidia Stage
4. Discussion
5. Conclusions
Supplementary Materials
Author Contributions
Funding
Institutional Review Board Statement
Informed Consent Statement
Data Availability Statement
Acknowledgments
Conflicts of Interest
References
- Hansberg, W.; Salas-Lizana, R.; Dominguez, L. Fungal catalases: Function, phylogenetic origin and structure. Arch. Biochem. Biophys. 2012, 525, 170–180. [Google Scholar] [CrossRef]
- Rhee, S.G. Overview on peroxiredoxin. Mol. Cells 2016, 39, 1–5. [Google Scholar] [CrossRef]
- Hillmann, F.; Bagramyan, K.; Strassburger, M.; Heinekamp, T.; Hong, T.B.; Bzymek, K.P.; Williams, J.C.; Brakhage, A.A.; Kalkum, M. The crystal structure of peroxiredoxin Asp f3 provides mechanistic insight into oxidative stress resistance and virulence of Aspergillus fumigatus. Sci. Rep. 2016, 6, 33396. [Google Scholar] [CrossRef]
- Agar, N.S.; Sadrzadeh, S.M.; Hallaway, P.E.; Eaton, J.W. Erythrocyte catalase. A somatic oxidant defense? J. Clin. Investig. 1986, 77, 319–321. [Google Scholar] [CrossRef]
- Izawa, S.; Inoue, Y.; Kimura, A. Importance of catalase in the adaptive response to hydrogen peroxide: Analysis of acatalasaemic Saccharomyces cerevisiae. Biochem. J. 1996, 320, 61–67. [Google Scholar] [CrossRef] [PubMed]
- Grant, C.M.; MacIver, F.H.; Dawes, I.W. Glutathione is an essential metabolite required for resistance to oxidative stress in the yeast Saccharomyces cerevisiae. Curr. Genet. 1996, 29, 511–515. [Google Scholar] [CrossRef]
- Grant, C.M.; Perrone, G.; Dawes, I.W. Glutathione and catalase provide overlapping defenses for protection against hydrogen peroxide in the yeast Saccharomyces cerevisiae. Biochem. Biophys. Res. Commun. 1998, 253, 893–898. [Google Scholar] [CrossRef] [PubMed]
- Seaver, L.C.; Imlay, J.A. Alkyl hydroperoxide reductase is the primary scavenger of endogenous hydrogen peroxide in Escherichia coli. J. Bacteriol. 2001, 183, 7173–7181. [Google Scholar] [CrossRef] [PubMed]
- Seaver, L.C.; Imlay, J.A. Hydrogen peroxide fluxes and compartmentalization inside growing Escherichia coli. J. Bacteriol. 2001, 183, 7182–7189. [Google Scholar] [CrossRef]
- Paulo, E.; Garcia-Santamarina, S.; Calvo, I.A.; Carmona, M.; Boronat, S.; Domenech, A.; Ayte, J.; Hidalgo, E. A genetic approach to study H2O2 scavenging in fission yeast-distinct roles of peroxiredoxin and catalase. Mol. Microbiol. 2014, 92, 246–257. [Google Scholar] [CrossRef]
- Panek, H.R.; O’Brian, M.R. KatG is the primary detoxifier of hydrogen peroxide produced by aerobic metabolism in Bradyrhizobium japonicum. J. Bacteriol. 2004, 186, 7874–7880. [Google Scholar] [CrossRef] [PubMed]
- Xia, Y.; Yu, H.J.; Zhou, Z.M.; Takaya, N.; Zhou, S.M.; Wang, P. Peroxiredoxin system of Aspergillus nidulans resists inactivation by high concentration of hydrogen peroxide-mediated oxidative stress. J. Microbiol. Biotechnol. 2018, 28, 145–156. [Google Scholar] [CrossRef] [PubMed]
- Zhou, Y.; Lv, H.Y.; Li, H.X.; Li, J.Y.; Yan, Y.F.; Liu, F.Y.; Hao, W.L.; Zhou, Z.M.; Wang, P.; Zhou, S.M. Nitroreductase increases menadione-mediated oxidative stress in Aspergillus nidulans. Appl. Environ. Microbiol. 2021, 87, e0175821. [Google Scholar] [CrossRef] [PubMed]
- Li, J.Y.; Sun, Y.W.; Liu, F.Y.; Zhou, Y.; Yan, Y.F.; Zhou, Z.M.; Wang, P.; Zhou, S.M. Increasing NADPH impairs fungal H2O2 resistance by perturbing transcriptional regulation of peroxiredoxin. Bioresour. Bioprocess. 2022, 9, 1. [Google Scholar] [CrossRef]
- Kawasaki, L.; Aguirre, J. Multiple catalase genes are differentially regulated in Aspergillus nidulans. J. Bacteriol. 2001, 183, 1434–1440. [Google Scholar] [CrossRef]
- Navarro, R.E.; Stringer, M.A.; Hansberg, W.; Timberlake, W.E.; Aguirre, J. catA, a new Aspergillus nidulans gene encoding a developmentally regulated catalase. Curr. Genet. 1996, 29, 352–359. [Google Scholar] [CrossRef]
- Kawasaki, L.; Wysong, D.; Diamond, R.; Aguirre, J. Two divergent catalase genes are differentially regulated during Aspergillus nidulans development and oxidative stress. J. Bacteriol. 1997, 179, 3284–3292. [Google Scholar] [CrossRef]
- Kadooka, C.; Onitsuka, S.; Uzawa, M.; Tashiro, S.; Kajiwara, Y.; Takashita, H.; Okutsu, K.; Yoshizaki, Y.; Takamine, K.; Goto, M.; et al. Marker recycling system using the sC gene in the white koji mold, Aspergillus luchuensis mut. kawachii. J. Gen. Appl. Microbiol. 2016, 62, 160–163. [Google Scholar] [CrossRef]
- Liu, Y.Y.; Li, H.X.; Li, J.Y.; Zhou, Y.; Zhou, Z.M.; Wang, P.; Zhou, S.M. Characterization of the promoter of the nitrate transporter-encoding gene nrtA in Aspergillus nidulans. Mol. Genet. Genom. 2020, 295, 1269–1279. [Google Scholar] [CrossRef]
- Zhou, S.M.; Fushinobu, S.; Kim, S.W.; Nakanishi, Y.; Maruyama, J.; Kitamoto, K.; Wakagi, T.; Shoun, H. Functional analysis and subcellular location of two flavohemoglobins from Aspergillus oryzae. Fungal Genet. Biol. 2011, 48, 200–207. [Google Scholar] [CrossRef]
- Zhou, S.M.; Narukami, T.; Masuo, S.; Shimizu, M.; Fujita, T.; Doi, Y.; Kamimura, Y.; Takaya, N. NO-inducible nitrosothionein mediates NO removal in tandem with thioredoxin. Nat. Chem. Biol. 2013, 9, 657–663. [Google Scholar] [CrossRef] [PubMed]
- Baltussen, T.J.H.; Zoll, J.; Verweij, P.E.; Melchers, W.J.G. Molecular Mechanisms of Conidial Germination in Aspergillus spp. Microbiol. Mol. Biol. Rev. 2019, 84, e00049-19. [Google Scholar] [CrossRef]
- Erttmann, S.F.; Gekara, N.O. Hydrogen peroxide release by bacteria suppresses inflammasome-dependent innate immunity. Nat. Commun. 2019, 10, 3493. [Google Scholar] [CrossRef]
- Jia, D.Q.; Li, Q.Z.; Luo, T.; Monfort, O.; Mailhot, G.; Brigante, M.; Hanna, K. Impacts of environmental levels of hydrogen peroxide and oxyanions on the redox activity of MnO2 particles. Environ. Sci. Process. Impacts 2021, 23, 1351–1361. [Google Scholar] [CrossRef] [PubMed]
- Punt, P.J.; Dingemanse, M.A.; Kuyvenhoven, A.; Soede, R.D.; Pouwels, P.H.; van den Hondel, C.A. Functional elements in the promoter region of the Aspergillus nidulans gpdA gene encoding glyceraldehyde-3-phosphate dehydrogenase. Gene 1990, 93, 101–109. [Google Scholar] [CrossRef] [PubMed]
- Calera, J.A.; Paris, S.; Monod, M.; Hamilton, A.J.; Debeaupuis, J.P.; Diaquin, M.; Lopez-Medrano, R.; Leal, F.; Latge, J.P. Cloning and disruption of the antigenic catalase gene of Aspergillus fumigatus. Infect. Immun. 1997, 65, 4718–4724. [Google Scholar] [CrossRef] [PubMed]
- Michan, S.; Lledias, F.; Baldwin, J.D.; Natvig, D.O.; Hansberg, W. Regulation and oxidation of two large monofunctional catalases. Free Radic. Biol. Med. 2002, 33, 521–532. [Google Scholar] [CrossRef] [PubMed]
- Steinhorn, B.; Sorrentino, A.; Badole, S.; Bogdanova, Y.; Belousov, V.; Michel, T. Chemogenetic generation of hydrogen peroxide in the heart induces severe cardiac dysfunction. Nat. Commun. 2018, 9, 4044. [Google Scholar] [CrossRef]
- Murphy, M.P.; Bayir, H.; Belousov, V.; Chang, C.J.; Davies, K.J.A.; Davies, M.J.; Dick, T.P.; Finkel, T.; Forman, H.J.; Janssen-Heininger, Y.; et al. Guidelines for measuring reactive oxygen species and oxidative damage in cells and in vivo. Nat. Metab. 2022, 4, 651–662. [Google Scholar] [CrossRef]
- Sakekar, A.A.; Gaikwad, S.R.; Punekar, N.S. Protein expression and secretion by filamentous fungi. J. Biosci. 2021, 46, 5. [Google Scholar] [CrossRef]
- Higuchi, Y. Membrane traffic in Aspergillus oryzae and related filamentous fungi. J. Fungi 2021, 7, 534. [Google Scholar] [CrossRef] [PubMed]
- Garcia, P.; Encinar Del Dedo, J.; Ayte, J.; Hidalgo, E. Genome-wide screening of regulators of catalase expression: Role of a transcription complex and histone and tRNA modification complexes on adaptation to stress. J. Biol. Chem. 2016, 291, 790–799. [Google Scholar] [CrossRef]
- Mendoza-Martinez, A.E.; Lara-Rojas, F.; Sanchez, O.; Aguirre, J. NapA mediates a redox regulation of the antioxidant response, carbon utilization and development in Aspergillus nidulans. Front. Microbiol. 2017, 8, 516. [Google Scholar] [CrossRef]
- Antunes, F.; Cadenas, E. Estimation of H2O2 gradients across biomembranes. FEBS Lett. 2000, 475, 121–126. [Google Scholar] [CrossRef] [PubMed]
- Branco, M.R.; Marinho, H.S.; Cyrne, L.; Antunes, F. Decrease of H2O2 plasma membrane permeability during adaptation to H2O2 in Saccharomyces cerevisiae. J. Biol. Chem. 2004, 279, 6501–6506. [Google Scholar] [CrossRef]
- Carmona, M.; de Cubas, L.; Bautista, E.; Moral-Blanch, M.; Medrano-Fernandez, I.; Sitia, R.; Boronat, S.; Ayte, J.; Hidalgo, E. Monitoring cytosolic H2O2 fluctuations arising from altered plasma membrane gradients or from mitochondrial activity. Nat. Commun. 2019, 10, 4526. [Google Scholar] [CrossRef]
- Sousa-Lopes, A.; Antunes, F.; Cyrne, L.; Marinho, H.S. Decreased cellular permeability to H2O2 protects Saccharomyces cerevisiae cells in stationary phase against oxidative stress. FEBS Lett. 2004, 578, 152–156. [Google Scholar] [CrossRef] [PubMed]

Disclaimer/Publisher’s Note: The statements, opinions and data contained in all publications are solely those of the individual author(s) and contributor(s) and not of MDPI and/or the editor(s). MDPI and/or the editor(s) disclaim responsibility for any injury to people or property resulting from any ideas, methods, instructions or products referred to in the content. |
© 2023 by the authors. Licensee MDPI, Basel, Switzerland. This article is an open access article distributed under the terms and conditions of the Creative Commons Attribution (CC BY) license (https://creativecommons.org/licenses/by/4.0/).
Share and Cite
Yan, Y.; Huang, X.; Zhou, Y.; Li, J.; Liu, F.; Li, X.; Hu, X.; Wang, J.; Guo, L.; Liu, R.; et al. Cytosol Peroxiredoxin and Cell Surface Catalase Differentially Respond to H2O2 Stress in Aspergillus nidulans. Antioxidants 2023, 12, 1333. https://doi.org/10.3390/antiox12071333
Yan Y, Huang X, Zhou Y, Li J, Liu F, Li X, Hu X, Wang J, Guo L, Liu R, et al. Cytosol Peroxiredoxin and Cell Surface Catalase Differentially Respond to H2O2 Stress in Aspergillus nidulans. Antioxidants. 2023; 12(7):1333. https://doi.org/10.3390/antiox12071333
Chicago/Turabian StyleYan, Yunfeng, Xiaofei Huang, Yao Zhou, Jingyi Li, Feiyun Liu, Xueying Li, Xiaotao Hu, Jing Wang, Lingyan Guo, Renning Liu, and et al. 2023. "Cytosol Peroxiredoxin and Cell Surface Catalase Differentially Respond to H2O2 Stress in Aspergillus nidulans" Antioxidants 12, no. 7: 1333. https://doi.org/10.3390/antiox12071333
APA StyleYan, Y., Huang, X., Zhou, Y., Li, J., Liu, F., Li, X., Hu, X., Wang, J., Guo, L., Liu, R., Takaya, N., & Zhou, S. (2023). Cytosol Peroxiredoxin and Cell Surface Catalase Differentially Respond to H2O2 Stress in Aspergillus nidulans. Antioxidants, 12(7), 1333. https://doi.org/10.3390/antiox12071333




